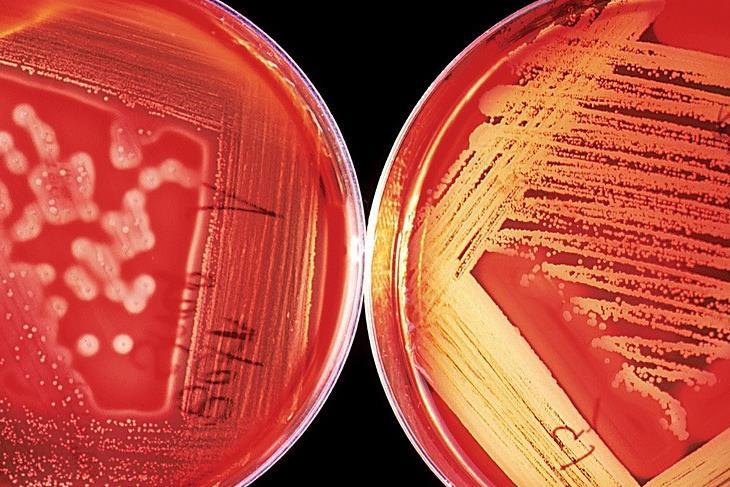
7704_agar60571_1280_753532_crop.jpg

UK government issues advice on E coli amid rise in cases
AMI expert Professor Nicola Holden has commented on news that the UK health authorities are investigating an increase in the number of Shiga toxin-producing E. coli (STEC) cases in the UK in recent weeks.
Any outbreak of STEC is a concern because it is a serious, notifiable pathogen that can cause severe and sometime fatal disease, she said.
”Disease can range from gastroenteritis, to bloody diarrhoea, to a liver disease haemolytic uremic syndrome. It tends to be more serious in very young children,” Professor Holden said.
”This variant of the group of Shiga-toxin producing E. coli (STEC) is within the O145 serotype, not the O157 that we would see more commonly when it first emerged in the 80s and 90s. Unfortunately serotype is not always a predictor of disease outcome, and O145 can be just as dangerous as O157.”
Serious complications
Infections caused by STEC bacteria can cause severe bloody diarrhoea and in some cases more serious complications. It is often transmitted by eating contaminated food but can also be spread by close contact with an infected person, as well as direct contact with an infected animal or its environment.
Whole genome sequencing of samples in the current investigation indicates that most cases are part of a single outbreak. Based on the wide geographic spread of cases, it is most likely that this outbreak is linked to a nationally distributed food item or multiple food items. The source of this outbreak is not yet confirmed but there is currently no evidence linking the outbreak to open farms, drinking water or swimming in contaminated sea, lakes or rivers. The public health agencies are working with the Food Standards Agency and Food Standards Scotland to investigate further.
Numbers expected to rise
As of 4 June, there have been 113 confirmed cases associated with this outbreak of STEC O145 in the UK, all reported since 25 May 2024 (81 in England, 18 in Wales, 13 in Scotland, 1 in Northern Ireland*). Typically, we see around 1,500 cases of STEC over a full year. Numbers of confirmed cases associated with this outbreak are expected to rise as further samples undergo whole genome sequencing.
Cases range in age from 2 years old to 79 years olds, with the majority of cases in young adults. Of the 81 cases identified to date in England, 61 have provided information to UKHSA related to food, travel and potential exposures and of these we know that 61% have been hospitalised.
Steps to take
While the source of this outbreak is currently unknown, there are steps you can take to reduce your risk of gastrointestinal infections, as well as limiting the spread to others:
- Regularly wash your hands with warm water and soap. Alcohol gels don’t kill all bugs that cause diarrhoeal illness
- Follow food hygiene measures such as washing fruit and vegetables and cooking food properly
- If you have diarrhoea and vomiting, you should not prepare food for others and avoid visiting people in hospitals or care homes to avoid passing on the infection.
- You should not return to work, school or nursery until 48 hours after your symptoms have stopped
Trish Mannes, Incident Director at UKHSA said: “Symptoms of infections with STEC include severe and sometimes bloody diarrhoea, stomach cramps, vomiting and fever. If you have diarrhoea and vomiting, you can take steps to avoid passing it on to family and friends. NHS.uk has information on what to do if you have symptoms and when to seek medical advice.
“Washing your hands with soap and warm water and using disinfectants to clean surfaces will help stop infections from spreading. If you are unwell with diarrhoea and vomiting, you should not prepare food for others while unwell and avoid visiting people in hospitals or care homes to avoid passing on the infection in these settings. Do not return to work, school or nursery until 48 hours after your symptoms have stopped.”
Identifying the source
Darren Whitby, Head of Incidents and Resilience at The Food Standards Agency said: “The FSA is working with UKHSA and relevant Public Health bodies to identify the source of the illness, which is likely to be linked to one or more food items.
“We always advise consumers and those looking after vulnerable people to ensure good hygiene practices are followed when handling and preparing food, regularly washing hands with soap and warm water and ensuring equipment, utensils and surfaces foods come into contact with are cleaned thoroughly to prevent cross contamination.
“You should not prepare food for others if you have had symptoms, or for 48 hours after symptoms stop. You can find more information about good hygiene practises – 4c’s, and E. coli on our website.”
AMI expertise
Bacteriologist Professor Nicola Holden, a member of Applied Microbiology International’s Food Security Advisory Group and who runs the Food Security Centre at Scotland’s Rural University College (SRUC) commented that any outbreak of STEC is a concern because it is a serious, notifiable pathogen that can cause severe and sometime fatal disease.
”Disease can range from gastroenteritis, to bloody diarrhoea, to a liver disease haemolytic uremic syndrome. It tends to be more serious in very young children,” she said.
”This variant of the group of Shiga-toxin producing E. coli (STEC) is within the O145 serotype, not the O157 that we would see more commonly when it first emerged in the 80s and 90s. Unfortunately serotype is not always a predictor of disease outcome, and O145 can be just as dangerous as O157.”
Combined effort
Professor Holden said UK-HSA will be working with colleagues from different public bodies, including the excellent food standards agencies in the devolved nations to identify the source.
”They have expert epidemiologists well versed in how to accurately estimate where the source is. This is normally an estimate because if it is a food product, it’s often been consumed or destroyed and is no longer present with the contaminating pathogens,” she said.
”Alternatively sources could be animals, from direct contact, e.g. petting zoos. UK-HSA also pioneered and use powerful genomics technologies to accurately identify which pathogens belong to the same outbreak.”
Prospect of more cases
Whether more cases can be expected depends on how long the outbreak has been going for, Professor Holden said.
”UKHSA have said they expect the numbers to increase as they continue with detection. There is a dependency on the type of source, e.g. the epidemiological curves look different for a perishable product compared to something long-lasting, which may be more prolonged.
”STEC has been with us since the 1980s. It is a continually evolving bacteria that, as a group, has a high degree of genetic diversity. Sometimes that makes it difficult to detect pathogens from surveillance efforts that may have the potential to cause disease, because their genetics don’t always follow a predictable pattern that definitively identify them as such.
Excellent efforts
”In the UK and internationally there are excellent efforts to continue to control and treat STEC. We work from the basic biosciences, to applied treatments in the clinic, to improved detection systems. This has helped to improve management where we know there are increased risks of transmission.
”We continue to improve the science, application and treatment as we learn more about evolution of the STEC group. Compared to other pathogens, the numbers of STEC are (thankfully) relatively low - however it is a priority pathogen because of the severity of disease. The UK has enhanced its surveillance programmes from biological threats like STEC, and we have excellent initiatives, like the FSA-led PATH-SAFE (pathogen surveillance in agriculture food and environment). The public bodies take this pathogen very seriously and continue to work hard on its control.”
